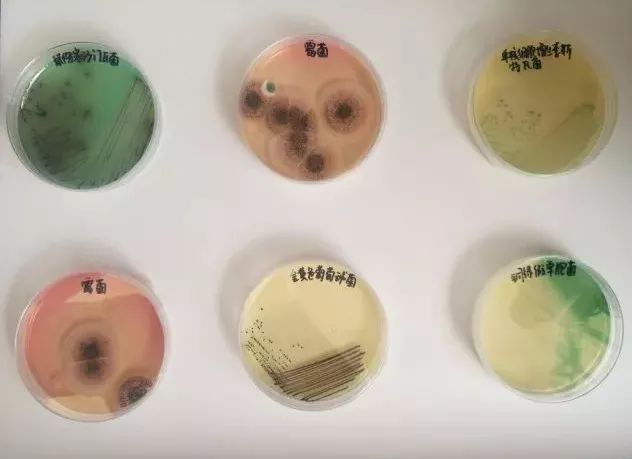

5月19日,2018年廣州科技創新活動周開幕式暨科學之夜啟動儀式在廣東科學中心盛大啟幕。中科院院士陳新滋等20多位大咖、創新企業領軍人物蒞臨現場,與1000多名市民共享“科技盛宴”。

廣電計量作為專業第三方計量檢測機構受邀參加活動,現場推出接地氣的手機輻射檢測、食品微生物形態觀測、趣味商品標簽知識科普等項目,促進公眾理解計量檢測對經濟社會發展,支撐美好生活的重要意義。廣電計量通過參與廣州科技創新活動周活動,積極履行社會責任,向公眾展示計量檢測技術在技術創新、產業發展、質量保障中的支撐作用,為我國產品質量安全、食品安全、環保安全保駕護航,獲得了廣東電視臺、廣州電視臺、南方網、廣東電臺等多家主流媒體廣泛關注報道,品牌影響力大為提升。

活動現場
借你一雙慧眼,識別手機輻射謠言“偽裝術”
“手機電量越少輻射越強?手機充電時輻射飆升百倍?手機輻射能煮熟雞蛋?”活動現場,很多市民就手機輻射傳聞進行了提問,得到工作人員一一耐心細致的解答。廣電計量技術人員帶來了專業的輻射檢測儀器,為市民提供檢測手機輻射服務,講解手機輻射科普知識。市民紛紛排隊檢測自己的手機,查看輻射的數值是否超標。特別是小朋友,高高舉起自己的手臂,檢測日常佩戴使用的電話手表。

趣味科普寓教于樂,傳播食品安全知識
大多數人都會談“菌”色變,但日常的生活又與細菌息息相關。活動現場,廣電計量帶來了食品微生物形態觀測項目。技術人員采用不同的“營養液”供養霉菌、大腸桿菌、葡萄球菌等微生物,它們生長成“五彩斑斕”的形態,非常形象具體,引發大批小朋友圍觀。
同時,技術人員還帶來了電子顯微鏡,讓小朋友們觀察用肉眼看不到的微生物和認識到這些細菌對人類健康的危害。參與活動的市民家長紛紛表示,這些趣味科普知識以及現場體驗項目非常實用,讓小朋友們增長科學知識,有助他們培養健康衛生的生活習慣。

看懂標簽,分清食品、保健品和藥品
日常生活中,我們經常看到一些保健品大行其道,究竟如何分清食品、保健品和藥品呢?廣電計量的技術人員向市民介紹:藥品是直接用于治療疾病的;保健食品是指聲稱具有國家相關法規規定的保健功能的食品;食品通俗點說就是為了填飽肚子的東西,不需要作定量服用規定。技術人員將準備好的標簽展示給在場市民查看,告訴市民要細細了解外包裝標簽的信息,才能選擇適合自己的商品。參與活動的市民紛紛表示,這些標簽科普知識非常實用,很好地傳播了科學知識,有效地幫助他們科學分辨了食品、保健品和藥品。

媒體報道

報道原文:
廣電計量:手機輻射現場測 保健品要“戴帽”
南方網訊(記者鄒長森 通訊員張建列)5月19日,以“創新發展、美好生活”為主題的2018年廣州科技創新活動周在廣東科學中心啟動。與往年“科技活動周”不同的是,今年的“科技創新活動周”,明顯強化了科技創新的色彩,更大力度地引進了企業大軍。
業界有一句話:不計量,不科學。量化是科學的基礎。作為專業第三方計量檢測機構,廣電計量(廣州廣電計量檢測股份有限公司)受邀參加開幕式科普展示,現場推出手機輻射檢測、食品微生物形態觀測、趣味檢測知識科普等項目,受到現場“科迷”的圍觀和點贊。
測試手機輻射
隨著智能手機的普及,以及智慧生活對手機的高度依賴,手機幾乎成為了我們生活中最忠誠的“伴侶”。與此同時,關于手機輻射的謠言也正通過手機在朋友圈傳播。“手機電量越少輻射是不是越強?手機充電時輻射會飆升嗎?”“聽說手機輻射能煮熟雞蛋?”在現場,“科迷”提出了一系列的問題。
廣電計量工作人員通過輻射檢測儀器“場強儀”,現場開展了檢測手機輻射服務,講解手機輻射科普知識。市民紛紛排隊檢測自己的手機,查看輻射的數值是否超標。廣電計量的技術人員通過檢測證明,輻射跟手機的發信功率相關,發信功率越大電磁輻射越大,一般來說,信號越弱的地方手機增大發信功率,而不是電量越弱時輻射越大,手機發信功率與電量沒有關系。此外,手機的功率根本無法與微波爐相提并論,所產生的輻射不可能做爆米花和煮雞蛋。
識別食品標簽
保健品和藥品傻傻分不清楚?食品標簽認真看!
近期,關于鴻茅藥酒冒充保健品,涉嫌欺騙消費者的新聞大肆傳播,引起了社會的廣泛關注。那么保健品和藥品究竟怎么分辨呢?
廣電計量的技術人員告訴記者,保健品必須有明顯的“藍帽子”標識,并且明確標注“輔助xxx”字樣,比如“輔助降血壓”。如果沒有標注,或標注的是“降血壓”,則涉嫌違法違規。“部分不良企業會將藥品的外包裝故意做成保健品或者飲料的包裝,誤導消費者。所以購物時仔細閱讀外包裝的食品標簽非常重要。”該技術人員稱,“食品標簽包含了大量的信息,比如食品的成分含量必須按由多到少的順序排列,否則涉嫌違法。同時,通過質量和含量的數值,我們可以大致推斷該食品是否適合自己食用。”
觀察食品微生物
活動現場,廣電計量帶來了食品微生物形態觀測、食品標簽以及保健品的科普項目,集顯微鏡觀察、食品農產品科普知識的互動內容。廣電計量工作人員稱,霉菌、大腸桿菌等聽著很恐怖、惡心的食品微生物,把它們制作成精美的標本之后廣受歡迎,引發大波“科迷”圍觀和學習。參與活動的市民紛紛表示,檢測技術在日常生活中應用廣泛,這些趣味科普知識以及現場演示項目非常實用,既傳播了科學知識,又提高了群眾對謠言的鑒別能力。
據悉,廣電計量是一家全國化、綜合性、軍民融合的國有第三方計量檢測機構,1964年開始從事計量檢測工作,是原國家信息產業部軍工電子602計量測試站。專業提供計量校準、可靠性與環境試驗、電磁兼容與安全測試、環保檢測、食品農產品檢測、化學分析、技術培訓與咨詢、產品認證及檢測裝備研發等一站式服務。廣電計量相關負責人表示,今年參與廣州科技創新活動周活動,向公眾展示計量檢測技術機構在國家技術創新、產業發展、質量保障中的技術支撐作用及其使命擔當,為我國產品質量安全、食品安全、環保安全保駕護航,為我國產業升級、質量提升和守護人民美好生活助力。